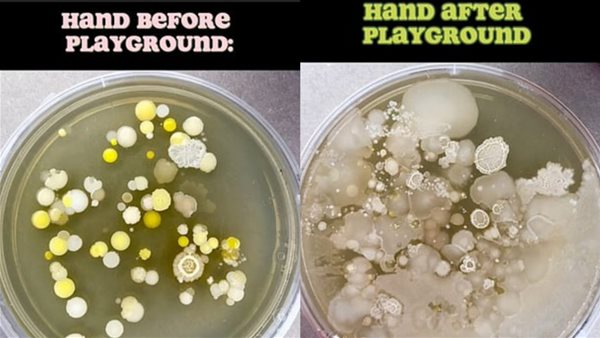
اليد قبل وبعد اللعب

عالم أحياء يحذر من المستعمرات البكتيرية الموجودة في ملاعب الأطفال
شارك أحد علماء الأحياء الدقيقة المدعى بـ تيم كول، نتائج مثيرة للقلق بعد اختبار مدى نظافة ملاعب الأطفال، وتوضيح كيفية العثور على آلاف البكتيريا الكامنة في أيدي الأطفال بعد ساعة واحدة فقط في الملعب، وفقًا لـ ديلي ميل البريطانية.
مفاجأة لأصحاب رهاب الجراثيم
تجول العالم حول الملاعب لعمل تجربة يبدأ فيها باختبار يده قبل زيارة الملعب، على طبق بتري، قبل الانتظار لمدة 10 دقائق، واكتشاف عدد قليل من المستعمرات البكتيرية، ثم يعرض عالم الأحياء الدقيقة العناصر التي لعب عليها الطفل، بما في ذلك تسلق صخور الألعاب، والانزلاق على الشرائح، والاستمتاع برقائق الخشب، وبعد ساعة، يضع الصبي الصغير يده في طبق بتري آخر، أخذه تيم إلى المنزل وفحصه، ليجد آلاف المستعمرات البكتيرية، بالإضافة إلى بقع كبيرة من الفطريات.
كان هدف تيم هو أن يكون قادرًا على إظهار القدر الهائل من نمو الجراثيم بعد الذهاب إلى موقع به حركة مرور عالية، من خلال التقاط هذه الصورة، بالإضافة لرغبته في التأكيد على أهمية غسل اليدين بعد زيارة أماكن مثل هذه.
وأشار تيم إلى أن أنظف شيء قام باختباره، وفوجئ من مدى نظافته هو مضخات الوقود في محطات الوقود، فأعتقد أنها ستكون مليئة بالبكتيريا بسبب كمية الاستخدام، لكنه وجد نمو ضئيل للغاية، حيث نمت خمس مستعمرات فقط.
عالم الأحياء يفاجئ متابعيه باستمرار
استجاب العديد من المشاهدين للفيديو باشمئزاز، وحصد الفيديو الذي تم نشره على منصة TikTok، أكثر من 287700 مشاهدة و20000 إعجاب، فغالبًا ما يحمل كول الذي لديه أكثر من 270 ألف متابع، أخبارًا سيئة للأشخاص الذين يعانون من رهاب الجراثيم، وسبق له أن تصدر عناوين الأخبار لمشاركته تفاصيل صادمة حول كل شيء بدءًا من مجففات الأيدي وحتى أحواض المطبخ.



















